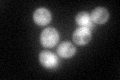
YDL235C
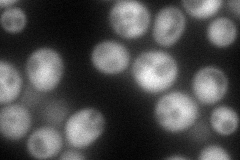
YDL235C
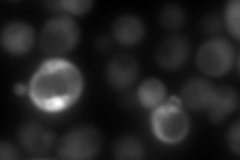
YDL235C
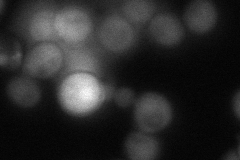
YDL235C
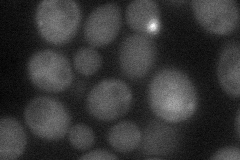
YDL235C
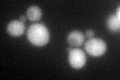
YDL235C
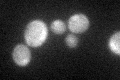
YDL235C

View description
Phosphorelay intermediate protein, phosphorylated by the plasma membrane sensor Sln1p in response to osmotic stress and then in turn phosphorylates the response regulators Ssk1p in the cytosol and Skn7p in the nucleus
Localization:
Intensity:
Fold change:
Significance:
-
C’ GFP library in SD
cytosol57.44 -
N' NOP1pr-GFP in SD
cytosol128.376 -
N' TEF2pr-mCherry in SD
cytosol37.0439 -
N' NATIVEpr-GFP in SD
cytosol64.4797 -
N' TEF2pr-VC and Cyto-VN in SD
cytosol41.2839 -
C’ GFP library in SD+DTT
cytosol50.840.88No -
C’ GFP library in SD+H2O2

cytosol49.710.86No -
C’ GFP library in Starvation Media
cytosol63.741.1No -
C’ GFP library on the background of Pup2-DaMP

cytosol -
C’ GFP library on the background of CCT mutant

cytosol46.15660.803492No
